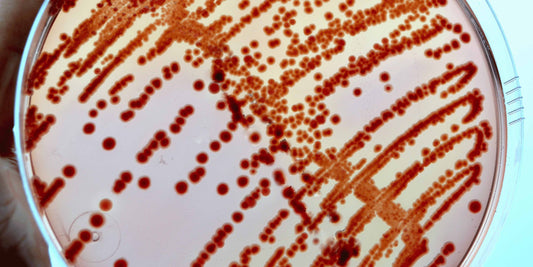

YOKUU BLOG

Natural, Chemical, Synthetic: What’s the Differ...
These days, we see product labels everywhere claiming to be "100% natural," "chemical-free," or "no synthetics." It sounds good, but do these terms really mean what we think they do?...
Natural, Chemical, Synthetic: What’s the Differ...
These days, we see product labels everywhere claiming to be "100% natural," "chemical-free," or "no synthetics." It sounds good, but do these terms really mean what we think they do?...

Ditch the stigma around microbes!
When you hear the word ‘microbe,’ do you think of microscopic monsters constantly at war with humanity? You’re not alone. We hear more horror stories linked to microbes than their...
Ditch the stigma around microbes!
When you hear the word ‘microbe,’ do you think of microscopic monsters constantly at war with humanity? You’re not alone. We hear more horror stories linked to microbes than their...

Allergies: What Are They and How Can You Manage...
Do you find yourself sneezing, with itchy eyes or feeling short of breath? You're not alone. Allergies affect about 35% of the population and are one of the most common...
Allergies: What Are They and How Can You Manage...
Do you find yourself sneezing, with itchy eyes or feeling short of breath? You're not alone. Allergies affect about 35% of the population and are one of the most common...

A fun & kid-proof microbe experiment
Microbes are everywhere, and often making our lives easier without us even noticing. For example, yeast helps make bread soft and fluffy by consuming sugar and producing carbon dioxide gas,...
A fun & kid-proof microbe experiment
Microbes are everywhere, and often making our lives easier without us even noticing. For example, yeast helps make bread soft and fluffy by consuming sugar and producing carbon dioxide gas,...

Did you know where the smell of rain comes from?
Taking a deep breath after a refreshing downpour reveals an unmistakable, earthy aroma that transports many back to childhood days spent playing outside. This enchanting smell, known as petrichor, has...
Did you know where the smell of rain comes from?
Taking a deep breath after a refreshing downpour reveals an unmistakable, earthy aroma that transports many back to childhood days spent playing outside. This enchanting smell, known as petrichor, has...

Fantastic microbes and where to find them
Summer's nearly here and we're itching for some adventure. While your YOKUU cleaning helpers take care of things at home, why not explore microbes in more exotic climes. Check out these...
Fantastic microbes and where to find them
Summer's nearly here and we're itching for some adventure. While your YOKUU cleaning helpers take care of things at home, why not explore microbes in more exotic climes. Check out these...

Is your dishwasher a microbe motel?
Picture this: you're squished in a sweltering, dark box, blasted with bleach and soap on a regular basis. Doesn't sound too comfy, right? And yet there are millions of living organisms...
Is your dishwasher a microbe motel?
Picture this: you're squished in a sweltering, dark box, blasted with bleach and soap on a regular basis. Doesn't sound too comfy, right? And yet there are millions of living organisms...

No Microbes, No Easter Eggs
Did you know microbes are essential for the delightful taste of chocolate?
No Microbes, No Easter Eggs
Did you know microbes are essential for the delightful taste of chocolate?

The secret life in your fridge and freezer
Ever wondered what kind of microscopic inhabitants are frolicking around in your fridge?
The secret life in your fridge and freezer
Ever wondered what kind of microscopic inhabitants are frolicking around in your fridge?